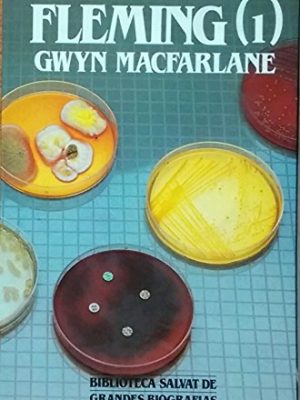
9788434581975_fleming-volumen-primero-bibloteca-salvat-de-grandes-biografias-52_front-1.jpg Fleming (volumen primero) (bibloteca salvat de grandes biografias, 52)

Resultados de tu búsqueda: Español
[yith_wcan_filters slug="default-preset"]
[yith_wcan_filters slug="default-preset"]
Mostrando 23305–23316 de 57351 resultadosOrdenado por popularidad
-

El imperio de las tinieblas
10,00 € -

Cuentos para regalar a personas sensibles (spanish edition)
6,93 € -

50 actividades para hacer casa (spanish edition)
6,42 € -

Los vigilantes del faro
5,98 € -

Paralelo 42
4,28 € -

Causas no naturales. crimen & cia
5,99 € -

Mujer, poder y dinero
9,88 € -
Fleming (volumen primero) (bibloteca salvat de grandes biografias, 52)
3,43 € -

Desde rusia con amor ( » james bond 007 » )
10,00 € -

Sueño eterno, el
3,90 € -

Trinidad
5,31 € -

Las arenas movedizas/the shivering sands (destinolibro, 177) (spanish edition)
1,90 €
